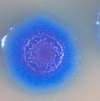

ПОПУЛЯРНОЕ ВЧЕРА ОБСУЖДАЮТ

МЫШЕЛОВКА ЗАХЛОПНУЛАСЬ? УЭК (БИОМЕТРИЧЕСКИЙ ПАСПОРТ) – ОКОНЧАТЕЛЬНОЕ ОТРЕЧЕНИЕ ОТ ХРИСТА, ДАЛЕЕ – ЗОМБИРОВАНИЕ И ПЕЧАТЬ
Главные новости / Публикации / Православие / Глобализация / Апостасия / Апокалипсис / Эл.концлагерь / УЭК | 20 августа 2012
0
1 100 331

Фикция «Майдана»Говорят, что дурак учится на своих ошибках, а умный на чужих. Значительная часть украинцев находится вне этой классификации, так как их ничему не учит ни свой опыт, ни чужой. Назвать подобную необучаемость глупостью трудно, потому что она выходит за рамки известных слабостей ума. В данном случае речь уже идёт не о банальном слабоумии...СОВЕТЫ НА ВСЯКИЙ СЛУЧАЙ, А СЛУЧАИ БЫВАЮТ РАЗНЫЕ... Для тех гражданских, кто решил пойти воеватьТак или иначе, сценарии могут быть разные. Суть всегда одна: нужно пережить первые недели две, а там «видно будет» (причем это не значит, что нужно две недели сидеть дома). Сценарий «А» вас сильно напрягать не должен, если в Москву перебросят чечей или еще какую каку, то людей для «работы» по ним найдется...ТЕРАКТ В КИТАЕ. Погиб 31 человек, 90 человек получили раненияПекин, 22 мая. Жертвами взрыва в китайском городе Урумчи стал по меньшей мере 31 человек, еще более 90 получили ранения, передает «Би-би-си» со ссылкой на государственные СМИ Китая. В четверг утром два автомобиля въехали в толпу людей на рынке возле парка Жэньминь в Урумчи, столице Синьцзян-Уйгурского автономного района...Синяя смерть от "British Petroleum"Эти бактерии питаются нефтью - впрочем, и почти любой другой органикой тоже. Их клетки полностью искусственные, со сконструированным компьютером геномом, вообще не содержат какой-либо природной ДНК, зато содержат в себе особые цепочки «водяных знаков» с тем, чтобы геном опознавался как искусственный...На месте пожара в Доме профсоюзов в Одессе обнаружены следы хлороформаСледствие обнаружило в мусоре и саже, изъятых в одесском Доме профсоюзов после пожара 2 мая, следы хлороформа, сообщил замглавы МВД Украины — начальник Главного следственного управления Виталий Сакал.Есть заключение экспертизы о том, что в мусоре и саже, а было проведено около 30 осмотров этих помещений...Лавров: одесскую трагедию следует расследовать под эгидой ООН и ОБСЕМинистр иностранных дел РФ Сергей Лавров заявил, что Россия не удовлетворится расследованием трагических событий в Одессе 2 мая, проведенном Верховной Радой, и будет добиваться международного расследования. "Мы не можем, естественно, брать на себя функции прокуроров и судей, но мы хотим, чтобы все факты...Забастовка профсоюзов Турции из-за трагедии на шахте: полиция разгоняет митингующих слезоточивым газомВ связи с гибелью почти 300 человек на шахте в Соме провинции Маниса в Турции в четверг продолжились массовые протесты против плохих условий безопасности труда в горнодобывающей промышленности. По призыву крупнейших профсоюзов страны сотни тысяч людей вышли на акции протеста в Стамбуле, Анкаре и других городах...Анатомия катастрофы в ОдессеНа девятый день после одесской трагедии, в самом центре Москвы - в храме святителя Николы на Берсеневке, поминали зверски убитых бандеровцами в Доме профсоюзов одесситов, называя их при этом новомученниками за святое русское дело. Так совпало, что практически одновременно на площади перед Киевским вокзалом столицы священники...ООН признала опасность химиотрассМы уже не раз публиковали материалы по химиотрассам. В последнее время их со скрипом начинают признавать лишь отчасти, выдавая малую часть информации об использовании химикатов с целью изменения климата. Реальный геноцид населения земли с помощью химиотрасс гораздо масштабней...Сирийские боевики перекрыли 2,5 млн жителям Алеппо доступ к питьевой водеЖители Аллепо - второго по величине города Сирии - уже неделю лишены доступа к питьевой воде из-за диверсии террористической группировки «Джебхат ан-Нусра» на городском водопроводе, сообщили СМИ со ссылкой на Сирийский центр мониторинга за соблюдением прав человека. Сообщается, что члены «Джебхат ан-Нусра»...Химтрейлы в г. Салехард (ФОТО). Письмо в редакциюПосмотрел, проанализировал, на фотографиях четко видно, где просто инверсионный след, а где распыление, при том иногда отчетливо видно как этот химслед довольно низко доходит до земли и держится в течении 2 часов. У меня лично, у моих знакомых, друзей есть чувство постоянной усталости, пассивности, вялости после этих следов...США готовы погубить сотни русских авиапассажировСтранная и даже страшная ситуация разворачивается сейчас в небе Украины - авиакомпании заявляют, что при пролете над территорией Незалежной ими фиксируются сбои в работе бортовых GPS. В свою очередь Росавиация заявила, что все авиакомпании "при полетах над Украиной должны быть готовы использовать навигацию, не основанную...США готовят Украине второй ЧернобыльКак выясняется, мечта самоназначенных властей заполучить атомную бомбу отнюдь не столь фантастична, как может показаться на первый взгляд. Причем не одну, а сразу четыре. Именно столько атомных электростанций на сегодняшний день функционируют на «незалежной» территории. Однако уже в ближайшее время прирученный...Химиотрассы - программа «Cloverleaf»Многие люди раньше воспринимали любую информацию о химиотрассах, как очередную страшилку любителей конспирологических теорий, а теперь даже законченные скептики относятся к этому всерьез. Не случайно химиотрассы называют чуть ли не бедой человечества N 1! Исследователи бьют тревогу: под химиотрассами на земле...Под Киевом появится радиоактивный могильникУкраина выделила участок под строительства хранилища отработанного ядерного топлива в зоне отчуждения чернобыльской АЭС. Решение приняли на заседании правительства. Сейчас на Украине работают четыре АЭС, которые обеспечивают половину потребления электроэнергии. Отработанное топливо отправляют на хранение...Еще раз о вреде ГМО«Инженер-агроном и производитель яблок Neal Carter в Саммерленде Британской Колумбии мечтает предложить потребителям яблоки, не похожие ни на что из того, что им доводилось видеть прежде.» Генетически модифицированные яблоки взорвут рынок?...Сланцевый газ в России. Путин обещает Shell административную поддержкуГлава нидерландско-британской компании Shell Бен Ван Берден сообщил президенту России Владимиру Путину, что его компания намерена расширять свое участие по проекту "Сахалин-2". Путин заверил его, что власти РФ намерены поддерживать Shell в ее работе на российском рынке, передает ИТАР-ТАСС...Сдерживание. Рейдерский захват УкраиныВ последнее время вошли в моду публикации перехваченных бесед дипломатов, однако мне хотелось бы рассказать не о телефонном разговоре, а о недавнем публичном выступлении — хотя и перед тщательно отобранной публикой — представителя Государственного департамента г-жи Виктории Нуланд...Супервулкан Йеллоустоун: В течение ближайших 10 лет Америка ищет себе новый временный домПравительство Соединенных Штатов ведут переговоры с разными странами о предоставлении дома для американцев в срочном порядке за $ 10 млрд в год в течение десяти лет. Правительство Соединенных Штатов считает, что Йеллоустонский супер-вулкан начнет извергаться в течение ближайших десяти лет, и предлагает заплатить...Киевский поезд смерти -2. Письмо в редакциюПо мотивам материала "Киевский поезд смерти", очень многие сочли нужным предположить, что в изложении фактов скажем так, была перегнута палка. И не было никакой возможности объяснять, что материал подобран опираясь не только на открытые источники, но и на такие, которые к делу не пришьешь, ибо, если пришьешь...Shell бурит украинские земли на востоке страны, Chevron — на западе (ВИДЕО)Пока это еще разведка боем. В деревне Алисово Shell бурит вторую скважину в Харьковской области. Ее дипломатично называют "Поисковая", но от промышленной она ничем не отличается. И если сланцевый газ здесь есть, а специалисты Shell в этом уверены, его будут добывать. Вместо двух скважин появятся тысячи...Что получит Украина вместе с кредитом МВФЯценюк, не успев стать премьером Украины, тут же «порадовал» граждан страны заявлением, что поскольку «госказна в Украине раскрадена и пуста», правительству придется принимать «крайне непопулярные решения, которые будут касаться субсидий, тарифов и сокращения социальных программ»...Киевский поезд смертиСашко Билый уже после смерти стал автором сенсации. Доверенные люди Музычко в «Правом секторе» пролили свет на события, предшествовавшие его трагической гибели. Вопреки навязываемой всем версии, причиной устранения Музычко людьми Авакова являются большая политика и деньги. Огромные деньги!...Мощное землетрясение и цунами обрушились на ЧилиПервая волна цунами, вызванного мощным землетрясением магнитудой 8,2, произошедшим в ночь на среду, обрушилась на побережье Чили, сообщает агентство Reuters. По меньшей мере два человека погибли, еще трое серьезно пострадали, заявили местные власти. Высота волн на северном побережье страны превышает два метра...Компания BASF зарегистрировала в России первый ГМОРеестр генетически модифицированных культур, разрешенных в пищу населению РФ пополнился двумя новыми позициями. Помимо трансгенного «старожила» Монсанто и некоторых других россияне теперь будут потреблять продукты из ГМ-сои, произведенной транснациональной корпорацией BASF...ООН: 1,4 тыс. детей умирают каждый день в мире из-за отсутствия доступа к питьевой воде1,4 тысяч детей умирают каждый день в мире из-за инфекций, вызванных отсутствием доступа к чистой питьевой воде и плохих санитарных и гигиенических условий. Об этом говорится в заявлении Детского фонда ООН (ЮНИСЕФ) в связи с отмечаемым 22 марта Всемирным днем водных ресурсов...БАНДЕРОВСКИЙ ОЛИГАРХАТ ГРОБИТ УКРАИНУ. Shell продолжит разработку сланцевого газа в Донецкой области (ВИДЕО)Компания Shell продолжит разработку сланцевого газа в Донецкой области. Как сообщила пресс-служба Донецкой облгосадминистрации, об этом заявил сегодня глава украинского представительства Shell Грехем Тайли на встрече с губернатором Донецкой области Сергеем Тарутой...Осколки Украины может спасти от хаоса только «человек с ружьём»Никаких выборов на территории, на которой ещё недавно было государство Украина, всё-таки не будет. И дело даже не в том, что власть в Киеве захватили персонажи, которые никогда не смогли бы прийти к ней путём выборов и, следовательно, ни в каких выборах не заинтересованы. Дело в том, что от реального распада бывшую Украину...«ЗАДАЧА ГЛОБАЛИСТОВ – ВВЕРГНУТЬ ЧЕЛОВЕЧЕСТВО В ХАОС». Беседа с О. Н. ЧетвериковойВ мире идет подготовка к установлению власти определенного сообщества, которое должно быть персонифицировано в лице сверхполитика, в нашей православной традиции называемого антихристом. Этот человек будет выполнять магическую миссию, выдавать себя за Христа, т. е. за сверхчеловека, будет управлять при помощи оккультных...Взрыв в центре Нью-Йорка. Есть погибшие и раненыеВ одном из зданий в центре Нью-Йорка произошел взрыв. В результате ЧП погибли две женщины, сообщает AP со ссылкой на полицейский департамент Нью-Йорка. Также 18 человек пострадали от взрыва, причиной которого, по словам мэра Нью-Йорка Билла де Блазио, стала утечка газа, передает BBC... |